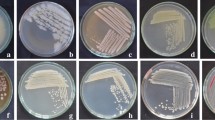

Abstract
Individual plant growth-promoting rhizobacterial (PGPR) strains (Bacillus thuringiensis B2, Bacillus subtilis B10 and Enterobacter cloacae B16) and their combination were used, with or without Pythium oligandrum, against Sclerotinia sclerotiorum. In vitro, all biological control agents (BCAs) reduced successfully hyphal growth of the targeted pathogenic fungus. They displayed antifungal activity by more than 50% compared to controls. In planta trials were conducted two years in the row and led to a significant decrease in stem rot severity two months after the antagonist’s application onto infected tomato plants. The reduction reached 75% using rhizobacterial mixtures and 72% using P. oligandrum alone, compared to controls. The plant growth-promoting potential of the three-strain consortium and P. oligandrum was also assessed. Increased height in disease-free plants was obtained with rhizobacterial mixtures (60%) compared to P. oligandrum (47%). The BCA’s mixture increased the height of treated plants inoculated with S. sclerotiorum (up to 80%) compared to inoculated and untreated plants. The fresh weight of the aerial parts and roots of disease-free plants was increased by 42 and 30% over control following their treatment with mixtures of rhizobacteria and P. oligandrum alone, respectively. On plants inoculated with S. sclerotiorum in both trials, the highest growth-enhancing effect was achieved using the combined treatment based on P. oligandrum and the three-strain rhizobacterial consortium (Po37 + B2 + B10 + B16). The rhizospheric microbial communities were assessed using Single Strand Conformational Polymorphism (SSCP). Differences in the genetic structure of the fungal and bacterial communities were observed following treatments applied in both trials.
Similar content being viewed by others
Avoid common mistakes on your manuscript.
Introduction
Several diseases affect tomato plants, some causing great damage such as anthracnose, fusariosis, and white mold. The latter one is caused by Sclerotinia sclerotiorum Lib. and has a wide host range consisting of approximately 278 genera and 408 plant species (Gupta et al. 2020). The pathogen resting structures, myceliogenically germinating sclerotia, are the initial source of infection of tomato plants leading to the development of a soft rotting of the aerial parts in contact with the soil line (Baturo-Cieśniewska et al. 2018). Disease management may be accomplished using conventional cultural practices (no-tillage, crop rotation, intercropping), and intensive use of chemicals (Juliatti et al. 2019). This last approach is incredibly expensive and associated with serious ecological impacts attributed to taster toxic residues (Sabaté et al. 2018). These constraints have increased the interest to develop safer alternatives such as biological control. This approach relies on the use of beneficial microbes as alternatives to chemical pesticides and fertilizers (Ab-Rahman et al. 2018; Niu et al. 2020).
Successful disease suppression was achieved using various microbial agents or formulations including bacteria (Ouhaibi Ben Abdeljalil et al. 2016a; Schmidt et al. 2021), fungi (Juliatti et al. 2019; Schmidt et al. 2021), and biofungicides (Macena et al. 2020). It is necessary to look for organisms suitable for use in biological control and to study their mechanisms of action and the optimal conditions for their application in plant protection and integrated management systems. One of such agents is the oomycete, Pythium oligandrum (Gerbore et al. 2014) which has received considerable attention as a potential biocontrol agent because of its ability to destroy a wide range of fungal and oomycete disease-causing pathogens (Gerbore et al. 2014; Baturo-Cieśniewska et al. 2018; Yacoub et al. 2020).
Microbial formulations based on Bacillus, Enterobacter, and P. oligandrum strains are attractive for commercialization due to their sustainable shelf life, their capacity to promote plant growth and their ability to produce antibiotics that are effective against various plant pathogens including S. sclerotiorum (Ouhaibi Ben Abdeljalil et al. 2016a; Farzand et al. 2019; Yacoub et al. 2020; Sharf et al. 2021).
Biocontrol agents should be as effective and reliable as chemical pesticides in the myriad microenvironments that exist in soil and on plant surfaces where disease control interactions occur (Hu et al. 2019). Most biocontrol approaches have used single biocontrol agents as antagonists to control a single (Miethling et al. 2000) or various pathogens (Berg and Smalla 2009; Saraf et al. 2014). This may partially account for the reported inconsistent performances of biocontrol formulations because single bio-agents are not likely to be active against various bio-aggressors in all soil environments in which they are released. Thus, it is thought that collectively a combination of microbes, with different environmental adaptations and mechanisms of action against target pathogens, is more likely to express important traits for more effective disease control over many different environmental conditions and agricultural ecosystems than an individual microbe (Guijarro et al. 2018; Ouhaibi Ben Abdeljalil et al. 2021).The success associated with the integration of biocontrol agents is attributed to their possible synergistic effects (Pylak et al. 2019). In past trials, a microbial consortium composed of Bacillus subtilis str. B10 (KT921327), B. thuringiensis str. B2 (KU158884) and Enterobacter cloacae str. B16 (KT921429) had efficiently controlled S. sclerotiorum-induced stem rot on tomatoes (Ouhaibi Ben Abdeljalil et al. 2016b, c). This same consortium exhibited interesting potential in a previous study when mixed with P. oligandrum against Rhizoctonia root rot on two tomato cultivars based on two consecutive years of testing (Ouhaibi Ben Abdeljalil et al. 2021).
In the present study, our objective was to assess the ability of this bacterial consortium, mixed or not with P. oligandrum, to control Sclerotinia stem rot and to stimulate the growth of tomato based on trials of two consecutive years. Possible changes occurring in the rhizospheric microbial community following these biological treatments were also investigated using the Single-Stranded Conformational Polymorphism (SSCP) technique.
Material and methods
Rhizobacteria traits and growth conditions
Three plant growth-promoting rhizobacterial (PGPR) strains, i.e. B. subtilis str. B10 (KT921327), B. thuringiensis str. B2 (KU158884) and E. cloacae str. B16 (KT921429), were used in the present study. They were originally recovered from the rhizosphere of visibly healthy (symptomless) tomato plants and were subjected to biochemical characterization and molecular identification in a previous study (Ouhaibi Ben Abdeljalil et al. 2016a). They were selected based on their antifungal and/or plant growth-promoting abilities (Ouhaibi Ben Abdeljalil et al. 2016b). Their specific traits are summarized in Table 1. They were routinely cultured on Nutrient Agar medium and stock cultures were maintained at -20 °C in Luria Bertani (LB) broth amended with 15% glycerol.
Pythium oligandrum inoculum preparation
Inoculum of P. oligandrum Po37 strain (oospores-mycelium homogenates) used in planta biocontrol assays was prepared and kindly provided by Biovitis (Saint Etienne de Chomeil, France). Its concentration was adjusted to 104 oospores/mL before being applied in planta.
Sclerotinia sclerotiorum culture conditions
The target pathogen was originally recovered from tomato plants exhibiting typical symptoms of white mold and/or stem rot disease. It was gratefully provided by the Plant Pathology Laboratory of the Regional Research Centre on Horticulture and Organic Agriculture of Chott-Mariem in Tunisia, as previously described in Ouhaibi Ben Abdeljalil et al. (2016a).
For in planta assays, the S. sclerotiorum isolate was cultured on Potato Dextrose Agar (PDA) medium amended with Streptomycin sulfate at 300 mg/L) (w/v) and incubated at 28 °C for five days. Mycelia were scraped at the surface of 10 Petri dishes and then mixed in 1 L of sterile distilled water (SDW) (Ouhaibi Ben Abdeljalil et al. 2016b). Mycelial fragment density was assessed using a hemacytometer and adjusted to 108 mycelial fragments/mL.
Assessment of the in vitro antifungal activity
Potential of PGPR strains
The ability of the three rhizobacterial strains to suppress S. sclerotiorum mycelial growth was evaluated using the dual culture technique. A loopful of each bio-agent (48-h-old culture) was added to 100 mL Nutrient Broth (NB) medium, then placed on a rotary shaker (150 rpm) and incubated at 28 ± 2 °C for 2 days. A 5-day-old fungal plug (6 mm in diameter) was placed on the side of a Petri plate (90 mm in diameter) containing a PDA medium. Then, 10 μL taken from 48-h-old bacterial suspension (~ 108 CFU/mL) was deposited into a well (6 mm in diameter, 3 mm in depth) on the opposite side. Plates inoculated with fungal agar plugs and treated with the same volume of SDW served as control. The assays were performed in triplicate.
After incubation at 28 °C for 7 days, the diameter of the pathogen colony and the inhibition zone were measured and compared with the untreated control. The percentage of fungal inhibition (FI) was calculated according to Rostami et al. (2013) as follows: GI (%) = (C- t)/ C × 100; where C is the diameter of the pathogen colony in control plates and t is the colony diameter in treated plates.
Potential of Pythium oligandrum
The dual culture technique was also used in this antagonism study. A mycelial plug (6 mm in diameter) taken from 7-day-old P. oligandrum Po37 culture was placed at one side of the Petri plate (90 mm in diameter) and another of S. sclerotiorum (6 mm in diameter), removed from a 5-day-old culture, was placed at the opposite side. For control plates, only pathogen plugs were placed on the PDA medium. Then, the plates were incubated at 25 °C for 5 days.
The diameter of S. sclerotiorum colony was measured and the mycelial growth inhibition percentage was calculated as described above. For the elucidation of hyphal interactions between the antagonist and the target pathogen, samples of mycelium were taken from the zone of interaction of the two agents and examined under an optical microscope followed by the taking of micrographs (Horner et al. 2012).
Combined biocontrol treatment in pot experiments
Plant material and growth condition
Tomato cv. Rio Grande seedlings, a cultivar known for its susceptibility to S. sclerotiorum infection, were used for all the in vivo trials. Seeds were surface sterilized with 3% sodium hypochlorite for 3 min and immediately rinsed with SDW three times. Next, they were sowed in alveolus plates (7 × 7 cm) filled with sterilized peat. Plates were placed under controlled conditions with day and night photoperiod and temperatures ranging between 21 − 18 ± 2 °C, respectively. They were watered regularly, to avoid water stress, until reaching the two-true-leaf growth stage.
Combined treatment preparation and co-inoculation assessment
Stock cultures of rhizobacteria were cultured onto Nutrient Agar (NA) medium and incubated at 28 °C for 48 h. After the incubation period, a bacterial colony of each strain was suspended in NB (300 mL) and incubated in a rotary shaker (175 rpm) for two days at 28 °C. Then, the 48-h-old cell culture was diluted in 1 L of SDW and adjusted to 108 CFU/mL (Wu et al. 2014). For the preparation of mixed biocontrol formulations, equal volumes of each rhizobacterial cell suspension were mixed, and the consortium obtained (3B) was tested alone or in mixture with P. oligandrum inoculum (3B + Po37).
Tomato seedlings used for the trial were deprived of water two days before the bioassay. Seedling treatment was performed as substrate drench around the stem using 30 mL of the rhizobacterial consortium alone or in a mixture with P. oligandrum. After one week, S. sclerotiorum inoculum (30 mL) was sprayed at the same level on each seedling. The next day, seedlings were transplanted into pots (16 cm in diameter) containing pathogen-infected peat (Benchabane et al. 2000; Le Foch et al. 2003).
Negative controls (uninoculated control seedlings) were treated with SDW only, while positive control plants were inoculated with S. sclerotiorum and treated with SDW or with a commercial fungicide, i.e. Previcur® (Bayer, France, propamocarb hydrochloride 722 g/L) applied at 0.5 mL/L. Uninoculated seedlings challenged with the rhizobacterial consortium and/or P. oligandrum were also used for comparison and the elucidation of their plant growth-promoting potential. This method of inoculation was chosen to avoid any trauma to tomato seedlings following root or stem injury.
Pots were grown under controlled conditions (60–70% relative humidity, 13/11 h light/dark photoperiod at 21/18 ± 2 °C light/dark temperature) and the whole experiment was repeated for two consecutive years (2012 and 2013).
Experimental layout
For the experiment, 135 tomato seedlings were used and distributed between nine treatments. The experimental design consisted of a randomized complete block design with 15 seedlings per individual treatment, under the two trials (2012 and 2013). The different treatments were: (i) C: untreated control, (ii) Sc: inoculated with S. sclerotiorum and untreated, (iii) Sc + f: S. sclerotiorum-inoculated and treated with a commercial fungicide, i.e. Previcur®, (iv) Po37: uninoculated and treated with P. oligandrum Po37, (v) Sc + Po37: inoculated with S. sclerotiorum and treated with P. oligandrum, (vi) 3B: uninoculated and treated with the rhizobacterial consortium, (vii) 3B + Po37: uninoculated and treated with P. oligandrum and the rhizobacterial consortium, (viii) Sc + 3B: inoculated with S. sclerotiorum and treated with the rhizobacterial consortium, (ix) Sc + 3B + Po37: inoculated with S. sclerotiorum and treated with P. oligandrum and the rhizobacterial consortium.
Assessment of disease control and plant growth-promoting potentials
At the end of the experiment (two months after the pathogen challenge), plants were uprooted, washed under running tap water to remove peat traces, and air-dried on filter papers. Parameters measured were plant height (cm) and fresh weight of aerial parts and roots (g) (Hassen and Labuschagne 2010). Disease severity was scored on roots based on a 0 − 5 scale where 0 = no symptoms, 1 = 0 − 25% root browning, 2 = 26 − 50% root browning, 3 = 51 − 75% root browning, 4 = 76 − 100% root browning and 5 = plant dieback (Takenaka et al. 2008). Disease incidence (DI) percentage was determined using the following equation:
Assessment of the shifts in the microbial communities following treatments
Characterization of the microbial (fungi and bacteria) communities’ structure and diversity was performed using profiles obtained by the CE-SSCP method, as previously described by Gerbore et al. (2014).
Sampling and DNA extraction
At the end of the experiment and the scoring of growth and severity parameters, 15 plants of each treatment were used for the characterization of the microbial community of roots following tested treatments.
Plants were uprooted gently from each pot to preserve the small feeder roots and were shaken to remove clumps of peat around the roots. Roots were cut into small fragments and crushed until further use for microbial and molecular analyses.
Total DNA was extracted as reported by Godon et al. (1997) with slight modifications. Briefly, root fragments were transferred into 2-mL polypropylene microcentrifuge tubes and kept frozen in a -80 °C freezer rack, then lyophilized for 12 h before DNA extraction.
DNA was extracted from 60 mg of ground lyophilized root fragments. A volume of 600 μL of lysis buffer CTAB (1x) was added to each 2 mL tube and incubated at 65 °C for 1 h. To remove proteins, 400 μL of chloroform-isoamyl alcohol (24/1, v/v) were added and tubes were shaken at 200 rpm for 10 min, then centrifuged at 13,000 rpm for 10 min at 4 °C. Aqueous phases were transferred to new 2-mL tubes. Nucleic acids were precipitated by the addition of 330 mL of cold isopropanol and then kept at -20 °C overnight. Nucleic acids were recovered by centrifugation at 13,000 rpm at 4 °C for 10 min.
Supernatants were discarded and DNA finally were pellets washed with 800 μL of ethanol 70%. After centrifugation at 13,000 rpm at 4 °C for 10 min, ethanol was discarded. Then DNA pellets were air-dried and re-suspended into 50 μL of SDW. DNA extracts were then quantified with a nanodrop (ND-1000, Thermo scientific, Labtech) and normalized at 10 ng/μL.
PCR-SSCP analyses
For fingerprinting analyses using Single-Strand Conformation Polymorphism (SSCP), pairs of primers recognizing the V5–V6 region of the 16S rRNA gene, i.e. 799f /1115r (Redford et al. 2010), and the mitochondrial large subunit rDNA gene, i.e.ML1/ML2 (White et al.1990) were used respectively for bacteria and fungi.
DNA was amplified by PCR in a reaction mixture (25 μL final volume) consisting of 1 μL of DNA template (10 ng/μL), 2.5 μL of Pfu buffer (10x), 2.5 μL of BSA (Bovine Serum Albumin) at 10 μg/μL (BioLabs), 1 μL of dNTP (10 mM), 0.5 μL of each primer, 0.5 μL of PfuTurbo (Stratagene) and 16.5 μL of sterile distilled water.
The cycling conditions for bacteria were: enzyme activation at 95 °C for 2 min; 25 cycles of denaturation at 95 °C for 45 s; hybridization at 54 °C for 30 s; extension at 72 °C for 1 min; and a final extension at 72 °C for 10 min. For fungi, the cycling parameters were 95 °C for 2 min, followed by 35 cycles at 95 °C for 30 s, 58 °C for 30 s, 72 °C for 1 min and a final extension at 72 °C for 10 min. The PCR products were visualized by 2% Tris–Borate-EDTA (TBE) agarose gel electrophoresis before SSCP analysis. The lengths of the fragments yielded by amplification were 250 bp and 350 pb for fungi and bacteria, respectively.
Single-Strand Conformation Polymorphism analyses were performed on an ABI PRISM 3130 genetic analyzer (Applied Biosystems) equipped with four 36-cm-long capillaries. One microliter of a PCR product was mixed with 18.8 µL Hi-Di formamide (Applied Biosystems) and 0.2 µL of the Genescan 400 HD ROX standard internal DNA molecular size marker (Applied Biosystems). The sample mixture was denatured at 95 °C for 5 min, instantly iced (10 min) and then placed onto the instrument. CE-SSCP is based on the electrophoretic mobility of single-stranded DNA fragments. This mobility is distinct according to their three-dimensional conformation. Samples were allowed to co-migrate with the fluorescent size standard (GeneScan 400 ROX) to allow the comparison of migration profiles between samples.
Statistical analyses
Analysis of experimental data was achieved by using one-way analysis of variance (ANOVA) with Statistical Package for the Social Sciences (SPSS) software for Windows version 16.0.
Each of the in vitro or in vivo experiments was repeated twice in time. Data were analyzed according to a completely randomized design in which 9 treatments were tested (i.e. 15 seedlings per individual treatment).
The means were separated using the Student–Newman–Keuls test to identify significant pair-wise differences at P ≤ 0.05. Correlations between disease severity and plant growth parameters were analyzed using the bivariate Pearson’s test at P < 0.01.
SSCP patterns were aligned with Stat Fingerprints (version 2.0) (Michelland et al. 2009) and were gathered in a single numerical database before being statistically described by a global PCA using R software (version 2.15.2).
Results
Antifungal potential of tested microbial agents
Inhibitory effects of PGPR strains
The inhibitory effect against S. sclerotiorum hyphal extension was examined after its dual culture with the tested PGPR strains as compared to control plates (Fig. 1). After 5 days of incubation at 25 °C, a significant (P ≤ 0.05) decrease in the growth of the pathogen was observed following its confrontation with PGPR strains compared to the untreated control (Table 2). The in vitro growth of the pathogen was inhibited by 41, 46 and 54% respectively by B. thuringiensis str. B2, B. subtilis str. B10, and E. cloacae str. B16. When confronted with S. sclerotiorum colonies, tested bacterial strains led to the formation of growth-inhibition zones with radial dimensions (distance between pathogen and bio-agent colony) estimated at respectively 7.6, 9 and 10.6 mm for B16, B2, and B10 (Table 2).
In vitro growth inhibition of Sclerotinia sclerotiorum due to diffusible metabolites from tomato-associated rhizobacterial strains compared to untreated controls. a Sclerotinia sclerotiorum control plate, b B10: Bacillus subtilis str. B10 (KT921327), c B16: Enterobacter cloacae str. B16 (KT921429) and d B2: Bacillus thuringiensis str. B2 (KU158884)
Inhibitory effects of Pythium oligandrum
Macroscopic evaluation
ANOVA analysis revealed a significant variation (P ≤ 0.05) in the diameter of S. sclerotiorum colony, measured after 5 days of incubation at 25 °C. P. oligandrum significantly inhibited the pathogen radial growth by more than 50% compared to the untreated control cultures.
After one week of incubation, the dual culture technique revealed that P. oligandrum was capable of overgrowing the pathogen colony.
Microscopic evaluation
At the light microscope level, the whole process of antagonism formation was observed. Microscopic examination showed that P. oligandrum (P) densely coiled around hyphae of S. sclerotiorum (S). P. oligandrum hyphae often coiled around the host (Fig. 2a), they grew parallel to the host and attached themselves to mycelium by forming hooks (Fig. 2a, arrow). In tip-to-host side interactions, the mycoparasite tips continued to grow after contact, they grew over the host hyphae, depending on the angle of contact (Fig. 2b).
Scanning light micrograph of Pythium oligandrum hyphae interacting with those of Sclerotinia sclerotiorum. a Condensed coiling of P. oligandrum around a hypha of S. sclerotiorum. Then P. oligandrum hypha formed hooks and attached itself to S. sclerotiorum hypha (arrow). b Mycelial abnormality of S. sclerotiorum caused by the antimicrobial activity of P. oligandrum. The arrow shows digested zone with penetration sites. P: Pythium oligandrum Po37; S: Sclerotinia sclerotiorum
Distribution of the fungal communities on the principal plans defined by the first two axes obtained in the principal component analysis (PCA) of SSCP profiles depending on rhizobacterial treatments (a) and Pythium oligandrum treatments (b) tested singly or as microbial consortium during 2013 trial. (a) The colors used here represent the profiles depending on tested treatments (3b: 3 tomato-associated rhizobacteria, applied as consortium (red); 3bpsc: 3 rhizobacterial consortium mixed with P. oligandrum, against S. sclerotiorum (blue); inoculated and untreated plants (green) and -: uninoculated and untreated plants (black)). (b) The colors used here represent (-p: P. oligandrum (red); psc: P. oligandrum tested against S. sclerotiorum (blue); sc-: inoculated and untreated plants (green) and -: uninoculated and untreated plants (black)). The variation (%) explained by each PCA axis is given in brackets. Ellipsoids draw the center of factors with 95% confidence
After contact with P. oligandrum, the mycoparasite sometimes penetrated S. sclerotiorum mycelium (Fig. 2b, arrow). Then, at a later stage of the antagonistic process, several hyphae of S. sclerotiorum were strongly degraded and cytoplasm of pathogenic hyphae became empty, as well as pathogenic hyphae appeared as abnormally shaped, empty pleiomorphic shells.
Effect of microbial treatments tested
Disease suppression ability
Tested rhizobacterial consortium, applied alone or mixed with P. oligandrum, significantly (at P ≤ 0.05) reduced the severity of S. sclerotiorum-induced stem rot compared to the untreated and pathogen-infected tomato plants (control). However, all tomato plants not challenged with the pathogen remained symptomless and healthy throughout the two-month experiment duration.
Disease incidence, estimated based on the presence of root browning, ranged from 27 to 100% in 2012 and from 73 to 100% in 2013 (Table 3).
The rhizobacterial consortium, applied singly or in combination with P. oligandrum, was found to be more efficient in reducing disease severity than the fungicide, during the two consecutive years of assays. Results given in Table 3 showed that disease severity (DS) was lowered by 72 to 93% in 2012 and by 72 to 75% in 2013 compared to respectively 52 and 49% using the fungicide control.
In 2012, the treatment composed of the three-strain consortium combined with P. oligandrum exhibited significantly higher effectiveness in decreasing Sclerotinia stem rot severity compared to the treatment with P. oligandrum alone. No such difference was observed in 2013.
Plant growth-promoting ability
Plant height
Results shown in Table 4 indicated that the treatment with the three-strain consortium and P. oligandrum had significantly (P ≤ 0.05) enhanced the plant growth during the two consecutive years of trials compared to the uninoculated and untreated control. The height increase varied from 47 − 62% and 49 − 60% depending on the treatments tested in the 2012 and 2013 trials respectively, with the microbial consortium (Po37 + B2 + B10 + B16) being the most efficient (62% in 2012 and 60% in 2013).
Data provided in Table 4 showed that all treatments tested in both trials significantly (P ≤ 0.05) augmented the height of S. sclerotiorum-inoculated and treated plants compared to the inoculated and untreated ones. For both years, the increase in plant height was 80 − 82% compared to 51 (2012) and 65% (2013) observed with the commercial fungicide Previcur®. For both trials, the highest height-increasing effect was obtained using the combined treatment based on P. oligandrum and the three-strain rhizobacterial consortium (Po37 + B2 + B10 + B16).
Aerial part growth
Based on their comparative ability to enhance the growth of the aerial part, the rhizobacterial consortium and/or P. oligandrum significantly (P ≤ 0.05) increased the aerial part’s fresh weight (APFW) compared to the untreated and pathogen-free plants. Results illustrated in Table 4 showed that the increment in this growth parameter ranged from 5 to 42% during the first trial (2012) and from 18 to 55% in the second one (2013) where the combined treatment (Po37 + B2 + B10 + B16) led to the highest parameter increase.
Data given in Table 4 also revealed that, in both trials, the APFW varied significantly (P ≤ 0.05) depending on the treatments tested. Indeed, all tomato plants inoculated with the pathogen and treated with the rhizobacterial consortium, applied singly or in combination with P. oligandrum, showed a significant increase in their APFW compared to S. sclerotiorum-inoculated and untreated control plants. The recorded APFW increment ranged from 34 to 36% in 2012 and from 38 to 45% in 2013 compared to 28% noted on Previcur®-treated and pathogen-inoculated plants.
Root growth
Data provided in Table 4 indicated that the root fresh weight (RFW), measured two months post-planting, varied significantly (P ≤ 0.05) depending on the treatments tested. For disease-free plants, RFW was improved by 30 to 51% in 2012 and by 35 to 50% in 2013 with the different treatments applied compared to the untreated control. The highest RFW increase was noted on plants treated with the three-strain rhizobacterial consortium in 2012 (B2 + B10 + B16) (51%) and the combined treatment (B2 + B10 + B16 + Po37) (50%) in 2013.
Regarding the comparative capacity to increase the RFW of tomato S. sclerotiorum-inoculated plants, the three-strain mixture combined with P. oligandrum (Po37 + B2 + B10 + B16) or P. oligandrum alone were the most effective treatments compared to pathogen-inoculated and untreated control in both trials. Results illustrated in Table 6 indicated that the root growth-promoting effect varied from 24 to 58% in 2012 and 55 to 68% in 2013 respectively versus 40 and 48% recorded on plants treated with the fungicide. Overall and in both trials, the greatest root growth-promoting effect was induced by the mixed treatment based on the rhizobacterial consortium and P. oligandrum (Po37 + B2 + B10 + B16).
Shifts occurring in the microbial communities structure following treatments
A total of 54 SSCP profiles were generated from the root samples collected from cv. Rio Grande tomato plants (27 in 2012 and 27 in 2013). Based on the number of peaks and the relative height of the baseline, the SSCP profiles revealed complex microbial communities (data not shown).
Principal Component Analyses (PCAs) were studied to assess the genetic structure of the rhizospheric bacterial and fungal communities of tomato plants inoculated with S. sclerotiorum and treated with the rhizobacterial consortium applied singly or in combination with P. oligandrum strain.
SSCP analyses of fungal community
The distributions of the samples on the principal plans generated by PCAs of fungal communities are represented in Fig. 3. Differences in fungal communities' genetic structure were observed with the P. oligandrum treatment applied alone or in combination with rhizobacteria during the 2013 trial. PCA eigenvalues indicate that the first two principal components, Dim 1 and Dim 2, account for 69% of the total fungal variability in 2013.
These results allowed three main types of community structure to be delineated: (i) rhizobacteria applied as a consortium in association with P. oligandrum, (ii) P. oligandrum treatment applied alone; and (iii) S. sclerotiorum inoculated and untreated plants.
SSCP structure of bacterial community
The distribution of samples on the principal plans generated by PCAs of bacterial communities is represented in Fig. 4. Differences in the genetic bacterial structure were observed during the two trials (2012 and 2013) depending on the rhizobacterial treatment.
Principal Component Analysis (PCA) of the bacterial communities colonizing the rhizosphere of tomato plants (cv: Rio Grande) during two consecutive years, 2012 (a) and 2013 (b), based on SSCP profiles. The colors used here represent the profiles depending on the rhizobacterial treatment used (_3b: 3 tomato-associated rhizobacteria, applied as consortium (red); sc_3b: 3 tomato-associated rhizobacteria, applied as consortium against S. sclerotiorum (blue); sc_-: S. sclerotiorum inoculated and untreated plants (green); and -_-: uninoculated and untreated plants (black)). The variation (%) explained by each PCA axis is given in brackets. Ellipsoids draw the center of factors with 95% confidence
PCA eigenvalues indicated that the first two principal components, Dim1 and Dim2, explained 75 and 77% of the total data variance respectively for 2012 and 2013. For both trials, the ellipses do not overlap when comparing plants inoculated with S. sclerotiorum only (sc_-) and treated by the consortium of rhizobacteria (sc_3b).
In 2012 (Fig. 4a), bacterial communities differed between uninoculated and untreated plants (-) and those on which the three rhizobacteria (-_3b) had been applied; while in 2013 (Fig. 4b), a shift occurred in the genetic structure of the bacterial communities of plants treated by the three rhizobacteria (-_3b) and then inoculated with S. sclerotiorum (sc_3b).
Discussion
Plant-pathogen interaction and disease development have always been a big challenge (Jeger et al. 2021). With time, farmers have applied various strategies to control pathogens’ growth. Physical and chemical strategies are important to control devastating plant diseases. However, the environmental pollution caused by excessive use of agrochemicals and the development of resistance in pathogens to certain fungicides led to considerable changes in people’s attitudes towards the use of pesticides in agriculture (Egüen et al. 2016). Biological control strategies are frequently reported as being much safer compared to other methodologies from the point of view of environmental protection (Singh et al. 2020). The best biological control is thought to be that one originated from the natural-occurring organisms since these organisms are adapted to the environmental conditions (Goussous et al. 2019). Microorganisms under natural habitats live in communities and some provide benefits to plants. Further, microbes when introduced to the soil as a consortium and interact with a host plant, partially mimic the natural soil conditions. The current research trend has therefore oriented toward investigating the role of microbial consortia in promoting plant growth and health against various invading pathogens (Sarma et al. 2015).
In our previous studies, we determined that three bacterial strains identified as B. thuringiensis B2 (KU158884), B. subtilis B10 (KT921327), and E. cloacae B16 (KT921429), whether or not associated with P. oligandrum, have the potential to control Rhizoctonia root rot and to promote growth for tomato plants (Ouhaibi Ben Abdeljalil et al. 2021). On this basis, the present work aimed at gaining more insight into the effect of the combination of antagonists (oomycete and rhizobacteria) to evaluate their ability to coexist in the tomato rhizosphere (cv. Rio Grande), to suppress white mold disease caused by S. sclerotiorum and to promote plant growth during two consecutive years’ assays.
The biological control of S. sclerotiorum has been demonstrated in numerous studies (Sabaté et al. 2018; Macena et al. 2020). One of these microorganisms is the oomycete P. oligandrum, which is known as a biocontrol agent against many plant pathogens (Gerbore et al. 2014; Pisarcik et al. 2021). Besides, the use of Bacillus strains as biocontrol agents to inhibit S. sclerotiorum has been previously tested in different crops (Ouhaibi Ben Abdeljalil et al. 2016a, b, c; Karthika et al. 2020). To improve the consistency of disease control, mixtures of bacteria and fungi as biocontrol agents (BCAs) are generally more effective than single BCAs, as published in many previous researches (Karthika et al. 2020; Ouhaibi Ben Abdeljalil et al. 2021). However, development of new active compounds with low phytotoxicity, reduced environmental impact and broad spectrum of activity are still required (Cabrefiga and Montesinos 2017).
Ideally, the biocontrol activity of candidate BCAs are evaluated using in vitro and in vivo screenings (Köhl et al. 2020). A dual culture technique was used for our two trials and the inhibitory activity of the isolated B. thuringiensis B2, B. subtilis B10, and E. cloacae B16 strains was evaluated against S. sclerotiorum. The overall results demonstrate that the three strains significantly inhibited the pathogen growth in vitro, compared to the untreated control, with values ranging from 41 to 54%. The distorted areas and mycelium anomalous formations of pathogens due to bacterial antagonists were frequently reported by many studies (Sabaté et al. 2018; Ouhaibi Ben Abdeljalil et al. 2021). Regarding P. oligandrum, dual antagonist-pathogen cultures revealed that the oomycete significantly inhibited the growth of S. sclerotiorum by more than 50% compared to the untreated control. The results of the in vivo investigation also showed that after contact between P. oligandrum and S. sclerotiorum mycelia, hyphae of the pathogen were degraded and cytoplasm became empty. P. oligandrum has also the capacity to parasite other fungi such as Fusarium oxysporum and Verticillium albo-atrum, by producing enzymes (cellulases and/or chitinases) that degrade the cell walls of target pathogens (Benhamou et al. 1999). Numerous studies have shown that P. oligandrum also secretes other extracellular enzymes, i.e. lipases, proteases and β-1,3-glucanases, which affect pathogenic fungi (Picard et al. 2000; Yacoub et al. 2020).
Velandia et al. (2021) suggested that the mechanism of in vitro mycelial growth suppression and inhibition success is mostly based on the production of antagonistic secondary metabolites, mainly the non-ribosomal cyclic lipopeptides (CLPs), which can affect phytopathogens directly (e.g. iturins and fengycins) or indirectly (e.g. surfactins). In our previous experiments, we found that the three bacterial strains were able to produce fengycin A and/or bacillomycin D (Ouhaibi Ben Abdeljalil et al. 2016a).
In general, primary selection of potential BCAs via in vitro dual culture assays has proven to be a valuable strategy to identify, on a higher throughput scale, BCAs with further confirmed in vivo biocontrol activity (Wang et al. 2015; Sharifazizi et al. 2017). The majority of published reports on plant disease biocontrol evaluate single strains against a specific pathogen (Liu et al. 2018). Despite the positive results reported, single BCAs have not been used on a wide range of host plants and have typically often exhibited inconsistent performances in the field (Pal and Gardener 2006). To solve this inconsistency issue, mixtures of BCAs are used because this strategy combines multiple modes of action of BCAs to control plant diseases more efficiently (Liu et al. 2018; Alfiky and Weisskopf 2021). We proved the efficacy of such microbial mixtures after having tested the association of the antagonistic oomycete P. oligandrum with the three selected rhizobacteria, B. thuringiensis B2, B. subtilis B10, and E. cloacae B16, against R. solani on tomato plants (Ouhaibi Ben Abdeljalil et al. 2021).
Many works initiated so far have concentrated on the effects of BCAs on the inhibition of fungal mycelial growth under in vitro conditions (Ettayebi et al. 2000). But very few studies have been conducted under in vivo conditions to show the properties of combined antagonistic oomycete with the rhizobacterial strains against S. sclerotiorum. This is why in the present work we tried to confirm the potential of microbial mixtures (P. oligandrum and 3 rhizobacteria) in the in vivo biological control of S. sclerotiorum during two consecutive years of greenhouse assays.
Tomato is an important crop that is grown worldwide and is an excellent model for studying plant–microbe interactions (Romero et al. 2015). A single organism may fail during adverse environmental conditions; therefore, a combination of more than one BCA is more likely to resist and help to reduce disease incidence through synergistic action. Moreover, microbial consortia can easily colonize the rhizosphere. Kannan and Sureendar (2009) proved the efficiency of consortia treatment in growth promotion and wilt resistance of tomatoes (Karthika et al. 2020). This study adds support to this strategy because it has provided evidence that tomato root treatment with the three-strain consortium, mixed or not with P. oligandrum, ameliorated plant growth parameters compared to the uninoculated and untreated control. Interestingly, our results showed a significant increase in plant growth, roots and aerial part fresh weight when we applied microbial mixtures. In the two consecutive years of trials, the microbial consortium (Po37 + B2 + B10 + B16) was the most efficient in enhancing plant growth by up to 60%, aerial part growth by more than 40% and roots fresh weight by 50%. In summary, the results reported here show that the PGPR strains mixture, associated or not with P. oligandrum, exhibited both biological control of S. sclerotiorum disease and plant-growth promotion. The magnitude of these results was better with mixtures than with individual BCAs strains and it revealed that combined application of oomycetal and bacterial biocontrol agents resulted in a synergistic effect on disease suppression. These results are partly supported by the studies of many authors (Zhang et al. 2019; Attia et al. 2020; Ouhaibi Ben Abdeljalil et al. 2021) who showed that PGPR and P. oligandrum, applied individually or in combinations, as biological agents can stimulate plant growth, improve plant health and productivity, and also soil health. The authors suggested that the observed increase in plant biomass may be due to the production of plant growth promoters and antibiotics. In agreement with this suggestion, the strains tested in our study previously exhibited multiple traits related to plant-growth promotion and broad-spectrum biocontrol activity (Ouhaibi Ben Abdeljalil et al. 2016a, b, c).
Besides, recent research carried by Attia et al. (2020) showed that the combined application of B. subtilis, Lysinibacillus fusiformis and Achromobacter xylosoxidans improved several growth parameters of tomatoes such as plant height, shoot biomass, root length, and leaf area. According to our results, the treatment with the mixture of BCAs was recording the highest percentage of protection. Indeed, the rhizobacterial consortium tested, applied alone or mixed with P. oligandrum, significantly reduced the severity of S. sclerotiorum-induced stem rot severity compared to the untreated and pathogen-infected tomato plants. For combined BCAs (P. oligandrum + 3 rhizobacteria), disease suppression ranged from 72 to 93% in 2012 and from 72 to 89% in 2013 compared to respectively 52 and 49% using the fungicide control. This result is similar to those obtained in previous studies, showing that BCAs are generally recognized as important tools for more sustainable disease management and represent valuable alternatives to classical pesticides (Liu et al. 2018; McDougall et al. 2018). Therefore, results of our in planta experiments indicate that the three-strain consortium, mixed or not with P. oligandrum, could be a promising alternative to the commercial fungicide Previcur®.
Following the plant treatment with BCAs, a change may occur within the native microbial community structure as indicated in the study of Buyer et al. (2010). On this basis, to assess the influence of the inoculated strains on native rhizospheric microbial communities of tomato cv. Rio Grande, Single Strand Conformational Polymorphism (SSCP) profiles of amplified 16S rRNA genes, and internal transcribed spacers (ITS) were compared. In summary, in this study, we focused on the microbial communities colonizing the root systems of tomato plants after a combination of treatments. We found that native fungal and bacterial communities responded differently when microbial BCAs were inoculated individually or in a mixture in the rhizosphere. Data available in the literature reported that BCAs can establish in different soil environments without perturbing the bacterial and fungal communities (Edel-Hermann et al. 2009). Vallance et al. (2009, 2012) and Renault et al. (2012) did not report shifts in the native fungal community of the rhizosphere after root inoculation by P. oligandrum, while they noticed a temporary shift in the native bacterial community (Vallance et al. 2012). These results may be compared with the investigation observed in the literature (Attia et al. 2017; Raymaekers et al. 2020) reporting that the BCAs group showed synergistic and antagonistic interactions with microbes present in the rhizosphere by indirectly boosting plant growth rate through the production of phytohormones.
To conclude, our data suggest that the tested individual PGPR strains (B. thuringiensis B2, B. subtilis B10 and E. cloacae B16) and their mixtures with or without the antagonistic oomycete P. oligandrum, exhibited both biological control of Sclerotinia stem rot and plant growth promotion. The magnitude of these results was better with the synergistic effect obtained with mixtures of P. oligandrum and the three rhizobacteria, than with individual PGPR strains. Overall, the present study provides an important data resource for further application of combination BCAs in tomato protection and production. Future studies should evaluate whether PGPR mixtures provide similar enhanced biological control and growth promotion in field tests.
Availability of data and materials
The data that support the findings of this study are available from the corresponding author, Dr. Nada Ouhaibi Ben Abdeljalil on request.
References
Ab Rahman SFS, Eugenie S, Corné MJP, Peer MS (2018) Emerging microbial biocontrol strategies for plant pathogens. Plant Sci 267:102–111. https://doi.org/10.1016/j.plantsci.2017.11.012
Alfiky A, Weisskopf L (2021) Deciphering Trichoderma–plant–pathogen interactions for better development of biocontrol applications. J Fungi 7:61. https://doi.org/10.3390/jof7010061
Attia MS, El-Sayyadb GS, Abd Elkodousd M, El-Batal A (2020) The effective antagonistic potential of plant growth-promoting rhizobacteria against Alternaria solani-causing early blight disease in tomato plant. Sci Hortic 266:109–289
Attia MS, Sharaf AE-MM, Zayed AS (2017) Protective action of some bio-pesticides against early blight disease caused by Alternaria solani in tomato plant. IJISET 4:67–94
Baturo-Cieśniewska A, Łukanowski A, Koczwara K, Lenc L (2018) Development of Sclerotinia sclerotiorum (Lib.) de Bary on stored carrot treated with Pythium oligandrum Drechsler determined by qPCR assay. Acta Sci Pol-Hortorum Cultus 17:111–121. https://doi.org/10.24326/asphc.2018.5.10
Benchabane M, Bakour R, Toua D, Boutekrabt A (2000) Mise en évidence de l‘effet antagoniste de Pseudomonas fluorescens vis-à-vis de la fusariose vasculaire de la tomate. OEPP/EPPO Bull 30:243–246
Benhamou N, Rey P, Picard K, Tirilly Y (1999) Ultrastructural and cytochemical aspects of the interaction between the mycoparasite Pythium oligandrum and soilborne pathogens. Phytopathology 89:506–517. https://doi.org/10.1094/PHYTO.1999.89.6.506
Berg G, Smalla K (2009) Plant species and soil type cooperatively shape the structure and function of microbial communities in the rhizosphere. FEMS Microbiol Ecol 68:1–13
Buyer JS, Teasdale JR, Roberts DP, Zasada IA, Maul JE (2010) Factors affecting soil microbial community structure in tomato cropping systems. Soil Biol Biochem 42:831–841
Cabrefiga J, Montesinos E (2017) Lysozyme enhances the bactericidal effect of BP100 peptide against Erwinia amylovora, the causal agent of fire blight of rosaceous plants. BMC Microbiol 17:39(10 pages). https://doi.org/10.1186/s12866-017-0957-y
Edel-Hermann V, Brenot S, Gautheron N, Aimé-Alabouvette CS, Steinberg C (2009) Ecological fitness of the biocontrol agent Fusarium oxysporum Fo47 in soil and its impact on the soil microbial communities. FEMS Microbiol Ecol 68:37–45. https://doi.org/10.1111/j.1574-6941.2009.00656.x
Egüen B, Melgarejo P, Cal A (2016) The effect of fungicide resistance on the structure of Monilinia laxa populations in Spanish peach and nectarine orchards. Eur J Plant Pathol 145:815–827. https://doi.org/10.1007/s10658-016-0871-4
Ettayebi K, El Yamani J, Rossi-Hassani BD (2000) Synergistic effects of nisin and thymol on antimicrobial activities in Listeria monocytogenes and Bacillus subtilis. FEMS Microbiol Lett 183:190–195. https://doi.org/10.1016/s0378-1097(99)00665-5
Farzand A, Moosa A, Zubair M, Rashid Khan A, Ayaz M, Colman Massawe V, Gao X (2019) Transcriptional profiling of diffusible lipopeptides and fungal virulence genes during Bacillus amyloliquefaciens EZ1509-mediated suppression of Sclerotinia sclerotiorum. Biol Control 110:317–326. https://doi.org/10.1094/PHYTO-05-19-0156-R
Gerbore J, Vallance J, Yacoub A, Delmotte F, Grizard D, Regnault RC, Rey P (2014) Characterization of Pythium oligandrum populations that colonize the rhizosphere of vines from the Bordeaux region. FEMS Microbiol Ecol 90:153–167. https://doi.org/10.1111/1574-6941.12380
Godon JJ, Zumstein E, Dabert P, Habouzit F, Moletta A (1997) Molecular microbial diversity of an anaerobic digestor as determined by small-subunit rDNA sequence analysis. Appl Environ Microbiol 63(7):2802–2813. https://doi.org/10.1128/aem.63.7.2802-2813.1997
Goussous SJ, Ibrahim MI, Tahhan RA, Al Antary TM (2019) Biological control of stem rot, Sclerotinia sclerotiorum by indigenous Bacillus subtilis isolates. Fresen Environ Bull 28(12):9517–9525
Guijarro B, Larena I, Casals C, Teixidó N, Melgarejo P, Cal AD (2018) Compatibility interactions between the biocontrol agent Penicillium frequentans Pf909 and other existing strategies to brown rot control. Biol Control 129:45–54. https://doi.org/10.1016/j.biocontrol.2018.11.011
Gupta NC, Sharma P, Rao M, Kumar-Rai P, Kumar-Gupta A (2020) Evaluation of non-injury inoculation technique for assessing Sclerotinia stem rot (Sclerotinia sclerotiorum) in oilseed Brassica. J Microbiol Meth 175:105983. https://doi.org/10.1016/j.mimet.2020.105983
Hassen AI, Labuschagne N (2010) Root colonization and growth enhancement in wheat and tomato by rhizobacteria isolated from the rhizoplane of grasses. World J Microbiol Biotechnol 26:1837–1846. https://doi.org/10.1007/s11274-010-0365-z
Hu X, Robertsb DP, Xiea L, Qina L, Lia Y, Liaoa X, Hana P, Yua C, Liaoa X (2019) Seed treatment containing Bacillus subtilis BY-2 in combination with other Bacillus isolates for control of Sclerotinia sclerotiorum on oilseed rape. Biol Control 133:50–57. https://doi.org/10.1016/j.biocontrol.2019.03.006
Horner NR, Grenville-Briggs LJ, van West P (2012) The oomycete Pythium oligandrum expresses putative effectors during mycoparasitism of Phytophthora infestans and is amenable to transformation. Fungal Biol 116:24–41. https://doi.org/10.1016/j.funbio.2011.09.004
Jeger M, Beresford R, Bock C, Brown N, Fox A, Newton A, Vicent A, Xu X, Yuen J (2021) Global challenges facing plant pathology: multidisciplinary approaches to meet the food security and environmental challenges in the mid-twenty-first century. CABI Agric Biosci 2:20. https://doi.org/10.1186/s43170-021-00042-x
Juliatti FC, Rezende AA, Juliatti MBC, Morai TP (2019) Trichoderma as a biocontrol agent against Sclerotinia stem rot or white mold on soybeans in Brazil: Usage and Technology. In book: Trichoderma: The Most Widely Used Fungicide (1–24). IntechOpen. https://doi.org/10.5772/intechopen.84544
Kannan V, Sureendar R (2009) Synergistic effect of beneficial rhizosphere microflora in biocontrol and plant growth promotion. J Basic Microbiol 49(2):158–164. https://doi.org/10.1002/jobm.200800011
Karthika S, Varghese S, Jisha MS (2020) Exploring the efficacy of antagonistic rhizobacteria as native biocontrol agents against tomato plant diseases. 3 Biotech 10:320. https://doi.org/10.1007/s13205-020-02306-1
Köhl J, Medeiros F HV, PlasCLVD, Lia de Haas G, Bosch TVD (2020) Efficacies of bacterial and fungal isolates in biocontrol of Botrytis cinerea and Pseudomonas syringae pv. tomato and growth promotion in tomato do not correlate. Biol Control 150:104375. https://doi.org/10.1016/j.biocontrol.2020.104375
Le Floch G, Rey P, Déniel F, Benhamou N, Picard K, Tirilly Y (2003) Enhancement of development and induction of resistance in tomato plants by the antagonist Pythium Oligandrum. Agronomy 23(5–6):455–460. https://doi.org/10.1051/agro:2003018
Liu K, McInroy JA, Hu CH, Kloeppe JW (2018) Mixtures of plant-growth-promoting rhizobacteria enhance biological control of multiple plant diseases and plant-growth promotion in the presence of pathogens. Plant Dis 102:67–72. https://doi.org/10.1094/PDIS-04-17-0478-RE
Macena AMF, Kobori NN, Mascarin GM, Vida JB, Hartman GL (2020) Antagonism of Trichoderma-based biofungicides against Brazilian and North American isolates of Sclerotinia sclerotiorum and growth promotion of soybean. Biocontrol 65:235–246. https://doi.org/10.1007/s10526-019-09976-8
McDougall JA, Helmick CG, Lim SS, Johnston JM, Gaddy JR, Gordon C, Ferucci ED (2018) Differences in the diagnosis and management of systemic lupus erythematosus by primary care and specialist providers in the American Indian/Alaska Native population. Lupus 27:1169–1176. https://doi.org/10.1177/0961203318763529
Michelland RJ, Dejean S, Combes S, Fortun-Lamothe L, Cauquil L (2009) StatFingerprints: a friendly graphical interface program for processing and analysis of microbial fingerprint profiles. Mol Ecol Resour 9:1359–1363. https://doi.org/10.1111/j.1755-0998.2009.02609.x
Miethling R, Wieland G, Backhaus H, Tebbe CC (2000) Variation of microbial rhizosphere communities in response to crop species, soil origin, and inoculation with Sinorhizobium meliloti L33. Microb Ecol 40:43–56. https://doi.org/10.1007/s002480000021
Niu B, Wang W, Yuan Z, Sederoff RR, Sederoff H, Chiang VL, Borriss R (2020) Microbial interactions within multiple-strain biological control agents impact soil-borne plant disease. Front Microbiol 11:585404. https://doi.org/10.3389/fmicb.2020.585404
Ouhaibi Ben Abdeljalil N, Vallance J, Gerbore J, Rey P, Daami-Remadi M (2016a) Bio-suppression of Sclerotinia stem rot of tomato and biostimulation of plant growth using tomato-associated rhizobacteria. J Plant Pathol Microbiol 7:331. https://doi.org/10.4172/2157-7471.1000331
Ouhaibi Ben Abdeljalil N, Renault D, Gerbore J, Vallance J, Rey P, Daami-Remadi M (2016b) Comparative efficacy of tomato-associated rhizobacteria strains used singly or in combination in suppressing Rhizoctonia root rot and enhancing tomato growth. J Microbial Biochem Technol 8:110–119. https://doi.org/10.4172/1948-5948.1000272
Ouhaibi Ben Abdeljalil N, Renault D, Gerbore J, Vallance J, Rey P, Daami-Remadi M (2016c) Evaluation of the effectiveness of tomato-associated rhizobacteria applied singly or as three-strain consortium for biosuppression of Sclerotinia stem rot in tomato. J Microbial Biochem Technol 8:312–320. https://doi.org/10.4172/1948-5948.1000302
Ouhaibi Ben Abdeljalil N, Vallance J, Gerbore J, Yacoub A, Daami-Remadi M, Rey P (2021) Combining potential oomycete and bacterial biocontrol agents as a tool to fight tomato Rhizoctonia root. Biol Control 155:104521. https://doi.org/10.1016/j.biocontrol.2020.104521
Pal KK, Gardener BM (2006) Biological control of plant pathogens. Plant Health Instructor. 2:1117–1142. https://doi.org/10.1094/PHI-A-2006-1117-02
Picard K, Ponchet M, Blein JP, Rey P, Tirilly Y, Benhamou N (2000) Oligandrin. A proteinaceous molecule produced by the mycoparasite Pythium oligandrum induces resistance to Phytophthora parasitica infection in tomato plants. Plant Physiol 124:379–395. https://doi.org/10.1104/pp.124.1.379
Pisarcik M, Hakl J, Szabo O, Hrevusov Z (2021) Efficacy of variable timing of Pythium oligandrum applications on red clover grown under field conditions. Crop Prot 149:105780. https://doi.org/10.1016/j.cropro.2021.105780
Pylak M, Oszust K, Frac M (2019) Review report on the role of bioproducts, biopreparations, biostimulants and microbial inoculants in organic production of fruit. Rev Environ Sci Biotechnol 18:597–616. https://doi.org/10.1007/s11157-019-09500-5
Raymaekers K, Ponet L, Holtappels D, Berckmans B, Cammue BPA (2020) Screening for novel biocontrol agents applicable in plant disease management - A review. Biol Control 144:104240. https://doi.org/10.1016/j.biocontrol.2020.104240
Redford AJ, Bowers RM, Knight R, Linhart Y, Fierer N (2010) The ecology of the phyllosphere: Geographic and phylogenetic variability in the distribution of bacteria on tree leaves. Environ Microbiol 12:2885–2893. https://doi.org/10.1111/j.1462-2920.2010.02258.x
Renault D, Vallance J, Déniel F, Wery N, Godon JJ, Barbier G, Rey P (2012) Diversity of bacterial communities that colonize the filter units used for controlling plant pathogens in soilless cultures. Microbial Ecol 63:170–187. https://doi.org/10.1007/s00248-011-9961-1
Romero FM, Marina M, Pieckenstain FL (2015) Novel components of leaf bacterial communities of field-grown tomato plants and their potential for plant growth promotion and biocontrol of tomato diseases. Res Microbiol 167:222–233. https://doi.org/10.1016/j.resmic.2015.11.001
Rostami S, Maleki M, Shahriari D (2013) The use of Bacillus amyloliquefaciens to control of Sclerotinia stem rot (Sclerotinia sclerotiorum) of cucumber. Intl J Farm & Alli Sci 22:965–970
Schmidt CS, Mrnkal L, Lovecká P, Frantík T, Fenclová M, Demnerova K, Vosátkal M (2021) Bacterial and fungal endophyte communities in healthy and diseased oilseed rape and their potential for biocontrol of Sclerotinia and Phoma disease. Sci Rep 11:3810. https://doi.org/10.1038/s41598-021-81937-7
Sabaté DC, Pérez Brandan C, Petroselli G, Erra-Balsells R, Audisio MC (2018) Biocontrol of Sclerotinia sclerotiorum (Lib.) de Bary on common bean by native lipopeptide-producer Bacillus strains. Microbiol Res 211:21–30. https://doi.org/10.1016/j.micres.2018.04.003
Saraf M, Pandya U, Thakkar A (2014) Role of allelochemicals in plant growth promoting rhizobacteria for biocontrol of phytopathogens. Microbiol Res 169:18–29. https://doi.org/10.1016/j.micres.2013.08.009
Sarma BK, Yadav SK, Singh S, Singh HB (2015) Microbial consortium-mediated plant defense against phytopathogens: Readdressing for enhancing efficacy. Soil Biol Biochem 87:25–33. https://doi.org/10.1016/j.soilbio.2015.04.001
Sharf W, Javaid A, Shoaib A, Khan IH (2021) Induction of resistance in chili againstSclerotium rolfsii by plant-growth-promoting rhizobacteria and Anagallis arvensis. Egypt J Biol Pest Co 31:16. https://doi.org/10.1186/s41938-021-00364-y
Sharifazizi M, Harighi B, Sadeghi A (2017) Evaluation of biological control of Erwinia amylovora, causal agent of fire blight disease of pear by antagonistic bacteria. Biol Control 104:28–34. https://doi.org/10.1016/j.biocontrol.2016.10.007
Singh A, Singh VK, Dwivedy AK, Tiwari-Dwivedi A, Dubey NK (2020) Biological control of plant diseases: Opportunities and limitations. In: Varma A, Tripathi S, Prasad R (eds) Plant Microbiome Paradigm. Springer, Cham. https://doi.org/10.1007/978-3-030-50395-6_7
Takenaka S, Sekiguchi H, Nakaho K, Tojo M, Masunaka A, Takahashi H (2008) Colonization of Pythium oligandrum in the tomato rhizosphere for biological control of bacterial wilt disease analyzed by Real-Time PCR and confocal laser-scanning microscopy. Biol Control 98:187–195. https://doi.org/10.1094/PHYTO-98-2-0187
Vallance J, Le Floch G, Déniel F, Barbier G, Lévesque CA, Rey P (2009) Pythium oligandrum biocontrol in the rhizosphere: influence on fungal and oomycete population dynamics. Appl Environ Microbiol 75:4790–4800. https://doi.org/10.1128/AEM.02643-08
Vallance J, Deniel F, Barbier G, Guerin-Dubrana L, Benhamou N, Rey P (2012) Influence of Pythium oligandrum on the bacterial communities that colonize the nutrient solutions and the rhizosphere of tomato plants. Can J Microbiol 58:1124–1134
Velandia CAM, Ongena M, Kloepper JW, Cotes AM (2021) Biosynthesis of cyclic lipopeptides by Bacillus velezensis Bs006 and its antagonistic activity are modulated by the temperature and culture media conditions. Curr Microbiol 78:3505–3515. https://doi.org/10.1007/s00284-021-02612-8
Wang X, Zhang X, Liu L, Xiang M, Wang W, Sun X, Che Y, Guo L, Liu-Wang G, Yin C, WBM, Zhang X, Liu X (2015) Genomic and transcriptomic analysis of the endophytic fungus Pestalotiopsis fici reveals its lifestyle and high potential for synthesis of natural products. BMC Genomics 16:28. https://doi.org/10.1186/s12864-014-1190-9
White TJ, Bruns T, Lee S, Taylor J (1990) Analysis of phylogenetic relationships by amplification and direct sequencing of ribosomal RNA genes. In: Innis MA, Gelfand DH, Sninsky JJ, White TJ (eds) PCR Protocols: A Guide to Methods and Applications. Academic Press, New York, NY, pp 315–322
Wu Y, Yuan J, Raza W, Shen Q, Huang Q (2014) Biocontrol traits and antagonistic potential oaf Bacillus amyloliquefaciens strain NJZJSB3 against Sclerotinia sclerotiorum, a causal agent of canola stem rot. J Microbiol Biotechnol 24:1327–1336. https://doi.org/10.4014/jmb.1402.02061
Yacoub A, Magnin N, Gerbore J, Haidar R, Bruez E, Compant S, Guyoneaud R, Rey P (2020) The biocontrol root-oomycete, Pythium oligandrum, triggers grapevine resistance and shifts in the transcriptome of the trunk pathogenic fungus Phaeomoniella Chlamydospora. Int J Mol Sci 21:6876. https://doi.org/10.3390/ijms21186876
Zhang W, Yan J, Li X, Xing Q, Chethana KWT, Zhao W (2019) Transcriptional response of grapevine to infection with the fungal pathogen Lasiodiplodia theobromae. Sci Rep 9:5387. https://doi.org/10.1038/s41598-019-41796-9
Acknowledgements
The authors would like to thank the Tunisian Ministry of Higher Education and Scientific Research for its financial support (funds allocated to the research laboratory LR21AGR03-Production and Protection for a Sustainable Horticulture (2PHD), IRESA-University of Sousse, Regional Research Centre on Horticulture and Organic Agriculture, Chott Mariem, Tunisia), as well as the French Ministry of Agriculture for its financial support (UMR SAVE/INRA Bordeaux-France and CFBP/INRA Angers-Nantes) and Biovitis.
Funding
This study was funded by the Tunisian Ministry of Higher Education and Scientific Research for its financial support (funds allocated to the research laboratory LR21AGR03-Production and Protection for a Sustainable Horticulture (2PHD), IRESA-University of Sousse, Regional Research Centre on Horticulture and Organic Agriculture, Chott-Mariem, Tunisia), as well as the French Ministry of Agriculture for its financial support (UMR SAVE/INRA Bordeaux-France and CFBP/INRA Angers-Nantes) and Biovitis.
Author information
Authors and Affiliations
Contributions
OBN, VJ, GJ, DM and RP conceived, designed, analyzed, wrote, corrected and approved the final draft.
Corresponding author
Ethics declarations
Ethics approval and consent to participate
Not applicable.
Consent for publication
Not applicable.
Conflict interests
The authors confirm that there is no conflict of interests and are also liable for the content and writing of this article.
Additional information
Publisher's Note
Springer Nature remains neutral with regard to jurisdictional claims in published maps and institutional affiliations.
Rights and permissions
Springer Nature or its licensor (e.g. a society or other partner) holds exclusive rights to this article under a publishing agreement with the author(s) or other rightsholder(s); author self-archiving of the accepted manuscript version of this article is solely governed by the terms of such publishing agreement and applicable law.
About this article
Cite this article
Ouhaibi Ben Abdeljalil, N., Vallance, J., Gerbore, J. et al. Single and combined effects of Pythium oligandrum Po37 and a consortium of three rhizobacterial strains on Sclerotinia stem rot severity and tomato growth promotion. J Plant Pathol 105, 157–171 (2023). https://doi.org/10.1007/s42161-022-01241-9
Received:
Accepted:
Published:
Issue Date:
DOI: https://doi.org/10.1007/s42161-022-01241-9